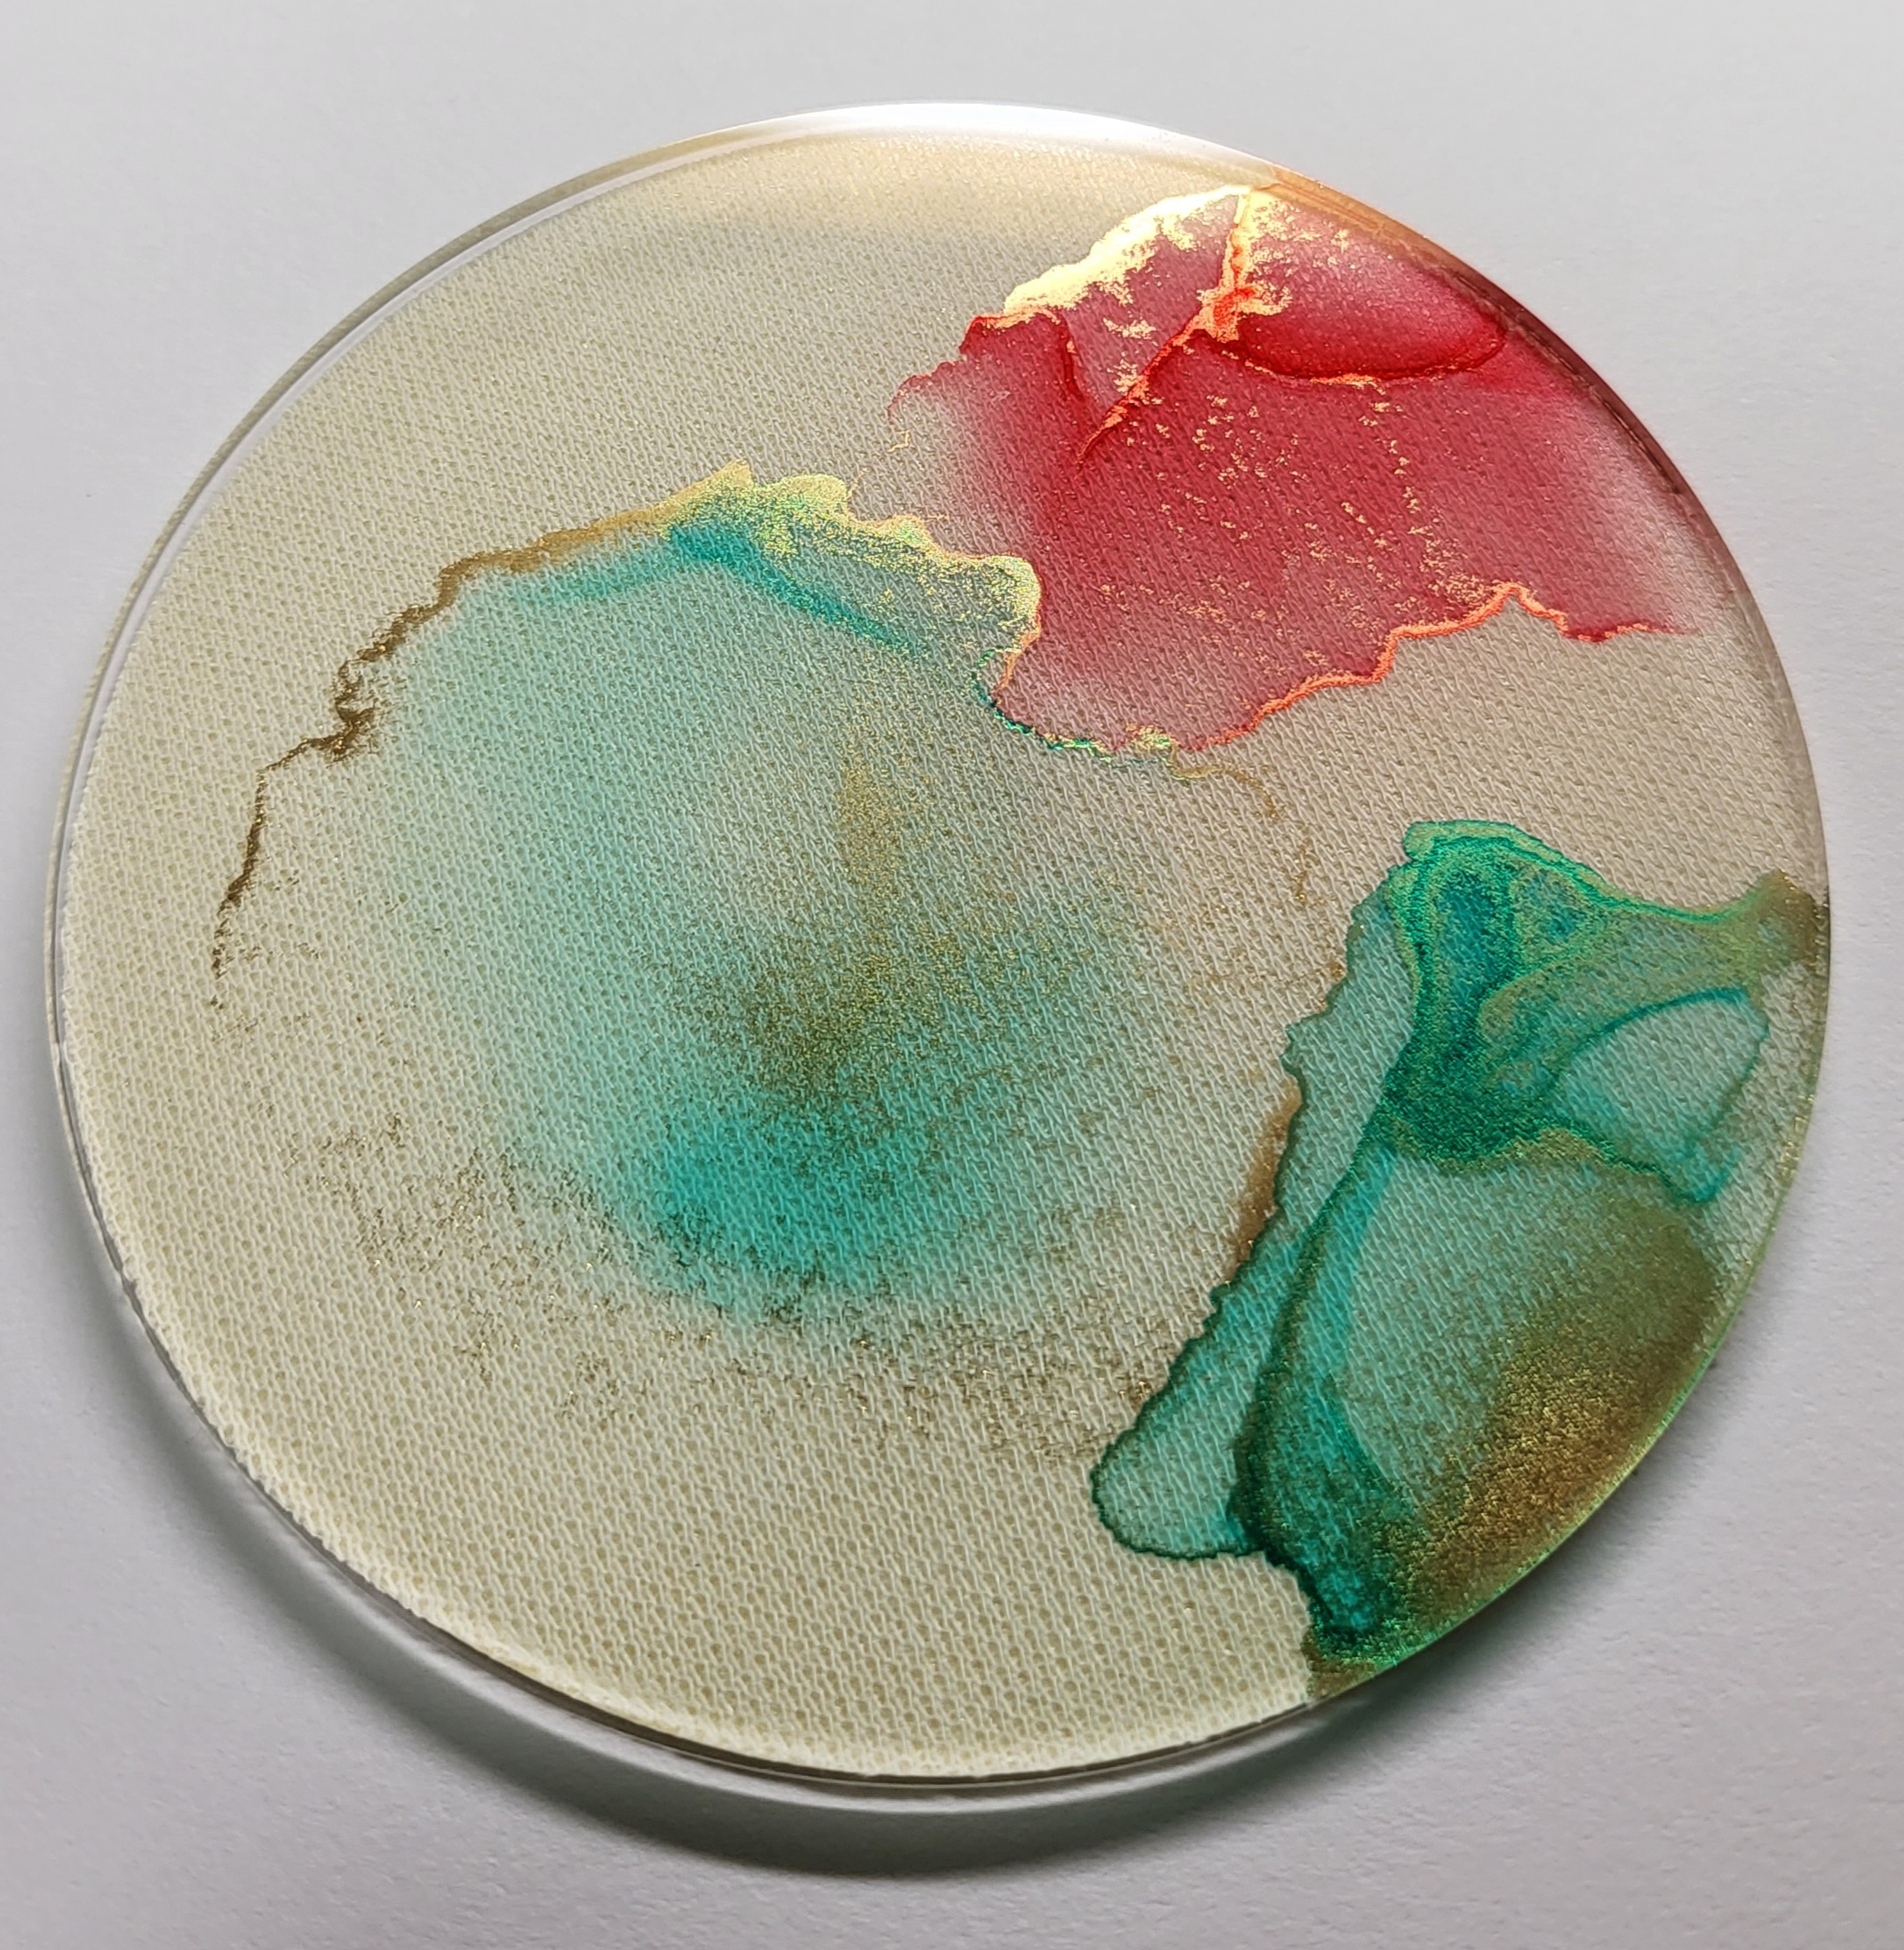

- No.1774
- 編集
- 削除
カテゴリ「描いた」に属する投稿[26件]
凍狂の旅行記







ホテル前にあった、超でっかいゴミ箱(アート作品)




ホテル周辺めちゃキレイでした!
アートアートしてて住民が上品で川もきれい
朝から健康的にお散歩しちゃったぁ…

秋葉原のラジオ会館
なんとなく、そういうところがあるんでしょ…?程度の知識で行きました。
建物全体がご覧の通りオラっ!オタク!ってかんじでちょっとゾクゾクしました。
知ってる作品ならもっと嬉しかったけど、これは仕方ない。

オカダヤ本店
品揃えが地元手芸店と違うのはワクワクしますねえ~本当に!
ただ、改めて思ったのは地元ユザワヤは本当に大規模なんだな。
売り場縮小した今でも広いもん。
凍狂でおもったんだけど、いろんなジャンルで地元ぜんぜん負けてないんだな、って…
よその土地行って気付くことってあるんすね

帰り
ドクターイエローが停車するってんでドエライ混雑になった新幹線ホーム
しかもわたしの乗車位置に車両先頭がくるっていうね
内心興味なかったんで「まじかよめいわく」ってちょっと思ってた。いやラッキーなんだろうけどっ…!







ホテル前にあった、超でっかいゴミ箱(アート作品)




ホテル周辺めちゃキレイでした!
アートアートしてて住民が上品で川もきれい
朝から健康的にお散歩しちゃったぁ…

秋葉原のラジオ会館
なんとなく、そういうところがあるんでしょ…?程度の知識で行きました。
建物全体がご覧の通りオラっ!オタク!ってかんじでちょっとゾクゾクしました。
知ってる作品ならもっと嬉しかったけど、これは仕方ない。

オカダヤ本店
品揃えが地元手芸店と違うのはワクワクしますねえ~本当に!
ただ、改めて思ったのは地元ユザワヤは本当に大規模なんだな。
売り場縮小した今でも広いもん。
凍狂でおもったんだけど、いろんなジャンルで地元ぜんぜん負けてないんだな、って…
よその土地行って気付くことってあるんすね

帰り
ドクターイエローが停車するってんでドエライ混雑になった新幹線ホーム
しかもわたしの乗車位置に車両先頭がくるっていうね
内心興味なかったんで「まじかよめいわく」ってちょっと思ってた。いやラッキーなんだろうけどっ…!
craftie のアルコールインクアートのキット

はい箱がオシャ
Love your home
「お前ん家が好き」…?こわ……
クラフティさんは毎月なんかしらの手芸グッズをキットごと送ってくれるハンドメイド体験サブスクです。
キットの別売りもしていて、今回はアルコールインクアートのキットを単品購入してみた、というお話。

紙とかアルコールとかインク、必要なものだいたい揃ってます。
初めて体験するには丁度いいんですよ、これくらいが。
インク多すぎても迷っちゃう。

ドライヤーが必要。
防水性の敷物してくれとのことなので、敷きました。目に厳しい色のシートしかうちには無かった。
さて本番。
基本的には
紙にインクとアルコール足らす→ドライヤーの風で混ぜるなり伸ばすなりする、ってことね!?
やり方動画がついてるので、なんとなくわかる!
ま、とりあえずやってみよ!

…
……???
いや、まあ動画でも「アルコールアートに失敗はありません。偶然性を楽しむものです」みたいなこと言ってたけど、偶然性が過ぎて説得力が一切ない……
自分が思ってるイメージのほうにドライヤーの風なりアルコールの量なり、調整できるようにならないと納得できないな
もうちょっとやってみよう

ナンデスカ?コレハ……
うーん
よし!
このキットで一番作ってみたかったコースター!
もうやっちゃいましょ!
偶然性に賭けるわよ

アクリルプレートに直接やるんですって。
紙じゃなくてもいけるんですねえ。
なんか昔、アクリルにアルコールは良くない(痛む)的なこと聞いたことあるんだけど…(コロナでアクリル板が流行った頃)

ふむ……!
悪くないんじゃないかしら?
これにレザーシールを貼って

アクリルコースターの完成でーす
夏っぽくていいとおもいまーす

紙にやるほうもちょっとコツ掴めてきました。
この紙、ユポ紙なんですって…高級じゃん……!

慣れてきた
青と赤で交互に模様出してる部分はかなりインクの伸びを支配できてる(たぶん)
そして

一枚絵で微妙でも、トリミングしたら良くなりますよ~というフレームが最後のキット

ナルホド
なるほど
あっ、コレもしかして…

よーし!
LETSのクリアシステム手帳に合う~!やったー!

もう一つ作れたアクリルコースター
これは!お気に入りです!
#Craftie

はい箱がオシャ
Love your home
「お前ん家が好き」…?こわ……
クラフティさんは毎月なんかしらの手芸グッズをキットごと送ってくれるハンドメイド体験サブスクです。
キットの別売りもしていて、今回はアルコールインクアートのキットを単品購入してみた、というお話。

紙とかアルコールとかインク、必要なものだいたい揃ってます。
初めて体験するには丁度いいんですよ、これくらいが。
インク多すぎても迷っちゃう。

ドライヤーが必要。
防水性の敷物してくれとのことなので、敷きました。目に厳しい色のシートしかうちには無かった。
さて本番。
基本的には
紙にインクとアルコール足らす→ドライヤーの風で混ぜるなり伸ばすなりする、ってことね!?
やり方動画がついてるので、なんとなくわかる!
ま、とりあえずやってみよ!

…
……???
いや、まあ動画でも「アルコールアートに失敗はありません。偶然性を楽しむものです」みたいなこと言ってたけど、偶然性が過ぎて説得力が一切ない……
自分が思ってるイメージのほうにドライヤーの風なりアルコールの量なり、調整できるようにならないと納得できないな
もうちょっとやってみよう

ナンデスカ?コレハ……
うーん
よし!
このキットで一番作ってみたかったコースター!
もうやっちゃいましょ!
偶然性に賭けるわよ

アクリルプレートに直接やるんですって。
紙じゃなくてもいけるんですねえ。
なんか昔、アクリルにアルコールは良くない(痛む)的なこと聞いたことあるんだけど…(コロナでアクリル板が流行った頃)

ふむ……!
悪くないんじゃないかしら?
これにレザーシールを貼って
アクリルコースターの完成でーす
夏っぽくていいとおもいまーす

紙にやるほうもちょっとコツ掴めてきました。
この紙、ユポ紙なんですって…高級じゃん……!

慣れてきた
青と赤で交互に模様出してる部分はかなりインクの伸びを支配できてる(たぶん)
そして

一枚絵で微妙でも、トリミングしたら良くなりますよ~というフレームが最後のキット

ナルホド
なるほど
あっ、コレもしかして…

よーし!
LETSのクリアシステム手帳に合う~!やったー!

もう一つ作れたアクリルコースター
これは!お気に入りです!
#Craftie
ワークショップで描いたモロコシの絵、サムネで見たらなかなかイケてるじゃないですか
一番表現したかった、クルッてなってる草(?)の部分の白浮き、思ったカンジになってるし。
やるじゃん…へへ……
一番表現したかった、クルッてなってる草(?)の部分の白浮き、思ったカンジになってるし。
やるじゃん…へへ……
私的メインイベントだった、「万年筆で絵を描くワークショップ」
古山先生のサイン本付き。
お話きいて、写真みながら何かしらを描く。
モチーフの写真は色々種類ありましたが、私はモロコシを選ぶぜ!
かたちが単純ですもん
こんなん飛ばしウキみたいなもんよね

粒さえ描けばそれっぽくなるやろ…
絵そのものはともかく、線ひくの速いほうだとは思うので(なんも考えずに描くからね)
でもこうやって写真でみたら、形が嘘まみれですね。ま、慣れてないししゃーなししゃーなし
最後先生に手直ししていただいて完成したのがこちら

モロコシ~
油彩色鉛筆での着彩でした。
折角カーボンインクだから、家で描いたらインクテンス使ってみたいな。
講座そのものの感想とは多少離れるんですが、この講座でいただいたプレピーが超当たり個体でした。
スルスルインク出るー!
いままでプレピー掠れるのしか当たったこと無かったんですよ。当たりやったー!































































描いてたらそのうち慣れるっしょ!